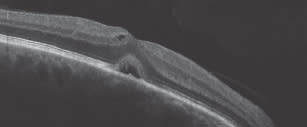

Detecting Common and Uncommon Conditions With SD-OCT
Spectral domain optical coherence tomography provides fast, accurate data without invasive testing.

By David Boyer, MD
Until the introduction of SD-OCT, epiretinal membrane (ERM) and vitreomacular traction (VMT), both common causes of blurred vision after cataract surgery, were severely underdiagnosed. Today, with routine use of SD-OCT as an adjunct to our clinical examination, we are able to avoid postoperative surprises. In fact, research has shown that OCT can pick up very subtle areas of foveal thickening that are not visible clinically.1 In this article, I discuss some common and not-so-common conditions that can be detected using SD-OCT.
Vitreomacular Traction
When using SD-OCT for preoperative evaluations, cataract surgeons can be more confident of a patient's status. This is especially important when the patient will receive a premium IOL, which leaves little margin for error. If any macular disease is present, it can significantly affect the quality of the patient's vision postoperatively (See Table 1).

Although ERMs may be best seen with a slit lamp and a contact lens, VMT can be difficult to see clinically. In many cases, patients may complain of minor distortions, and the examination looks relatively normal, or the vision may be off just slightly, which could be attributed to cataract, when in fact it is related more to vitreo-macular interface disorder.
In general, we are finding VMT with increasing frequency since we have started using the Cirrus HD-OCT (Figure 1).

Figure 1. Epiretinal membranes usually are visible by contact lens or 90-diopter lens, while vitreomacular traction is best seen by SD-OCT.
Hydroxychloroquine (Plaquenil) Toxicity
Recently, the American Academy of Ophthalmology published new criteria for clinicians following patients who are taking hydroxychloroquine (Plaquenil), recommending the use of SD-OCT.2 SD-OCT is a good adjunct to the clinical examination to enable us to detect early cases of Plaquenil toxicity, possibly even before we can see it on fluorescein angiography, as Case 1 illustrates. Following patients prospectively with SD-OCT, a non-invasive test, is good for patients and will detect early disease. SD-OCT will reveal localized thinning in the parafoveal region and loss of the IS/OS junction.
Retinal Detachment vs. Schisis
SD-OCT also has utility for differentiating retinal detachment from retinal schisis (Case 2). Using SD-OCT, we can see the thin layer of the inner retina with the outer retina in place versus the full thickness retina characteristic of a retinal detachment. This is extremely critical for diagnosis and treatment decisions because retinal detachment is an emergent situation, but schisis may be observed.
Cirrus Helps Differentiate in Diagnosis
Other conditions that may mimic one other and be difficult to differentiate without SD-OCT are central serous retinopathy and wet AMD. This technology is also useful for detecting subtle changes, such as cystoid macular edema (Figure 2) and pigment epithelial alteration, using a noninvasive test. What I appreciate about the Cirrus OCT is that it is accurate and easy to review. Clinicians can capture information quickly without the need for further analysis. ■
Figure 2. SD-OCT is helpful for detecting subtle changes as in cystoid macular edema.
| Case 1: Plaquenil Toxicity |
|---|
| A 70-year-old woman is evaluated for decreased vision in her left eye. She has Sjögren syndrome, posterior vitreous detachment and epiretinal membrane in both eyes and a history of pigmentary changes observed in the left eye for 6 years. She has hypertension, hypothyroidism and rheumatoid arthritis. She is taking enalapril (Vasotec), levothyroxine (Synthroid), and hydroxychloroquine (Plaquenil) (200-300 mg for 20 years). Note the mild ERM present and eventually the loss of the OS/IS junction with pigment atrophy. Owing to these changes, it was recommended the patient discontinue the Plaquenil. 
Figure 1. Fundus, July 2009 
Figure 2. Fundus, March 2010 
Figure 3. Fundus, January 2011 
Figure 4. Fluorescein angiogram, March 2010 
Figure 5. Fluorescein angiogram, January 2011 
On visits in July 2009, March 2010 and January 2011 (top to bottom), the patient's visual acuity OS was 20/20, 20/25−1 and 20/25+2. 
On visits in July 2009, March 2010 and January 2011 (top to bottom), the patient's visual acuity OD decreased from 20/20 to 20/20−2 to 20/25−2. |
| Case 2: Retinal Detachment vs Schisis |
|---|
A 45-year-old woman is evaluated for sudden vision loss in the right eye. Clinical examination revealed an elevation of the right inferotemporal retina, suggesting retinal detachment. Cirrus HD-OCT revealed that it was not a retinal detachment, but was instead a retinal schisis, which can be safely observed in most patients and does not require immediate treatment.
|
REFERENCES
1. Brown JC, Solomon, SD, Bressler SB, Schachat AP, DiBernardo C, Bressler NM. Detection of diabetic foveal edema: contact lens biomicroscopy compared with optical coherence tomography. Arch Ophthalmol. 2004;122:330-335.
2. Marmor MF, Kellner U, Lai TY, Lyons JS, Mieler WF; American Academy of Ophthalmology. Revised recommendations on screening for chloroquine and hydroxychloroquine retinopathy. Ophthalmology. 2011;118:415-422.
Dr. Boyer is a retina specialist with Retina-Vitreous Associates in Beverly Hills, Calif. He is a professor of ophthalmology at the University of Southern California Keck School of Medicine in Los Angeles. He can be reached at vitdoc@aol.com.








